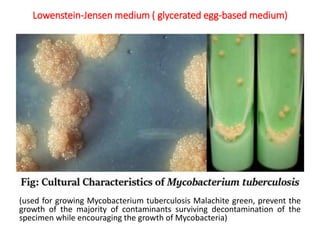
Lowenstein-Jensen medium ( glycerated egg-based medium)
(used for growing Mycobacterium tuberculosis Malachite green, prevent the
growth of the majority of contaminants surviving decontamination of the
specimen while encouraging the growth of Mycobacteria)
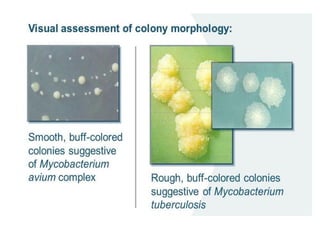

Mycobacterium tuberculosis
Mycobacterium tuberculosis (M. tuberculosis) is a pathogenic bacterium that causes tuberculosis (TB), a serious infectious disease primarily affecting the lungs.
Characteristics
1. *Acid-fast*: M. tuberculosis is an acid-fast bacillus, meaning it retains certain stains even when treated with acid.
2. *Slow-growing*: M. tuberculosis has a slow growth rate, which can make diagnosis and treatment challenging.
3. *Ziehl-Neelsen stain*: M. tuberculosis can be identified using the Ziehl-Neelsen stain, a special staining technique.
Transmission
1. *Airborne transmission*: M. tuberculosis is primarily spread through the air when an infected person coughs, sneezes, or talks.
2. *Close contact*: People in close contact with an infected individual are at higher risk of transmission.
Pathogenesis
1. *Inhalation*: M. tuberculosis is inhaled into the lungs, where it infects alveolar macrophages.
2. *Intracellular survival*: The bacteria can survive inside macrophages, evading the host's immune response.
3. *Granuloma formation*: The immune system responds by forming granulomas, which are clusters of immune cells that attempt to contain the infection.
Clinical manifestations
1. *Pulmonary TB*: Symptoms include cough, chest pain, coughing up blood, and difficulty breathing.
2. *Extrapulmonary TB*: TB can affect other parts of the body, such as the kidneys, spine, or brain.
Diagnosis
1. *Sputum smear microscopy*: Examination of sputum samples for acid-fast bacilli.
2. *Culture*: Growing M. tuberculosis in culture is a definitive diagnostic method.
3. *Molecular tests*: PCR (polymerase chain reaction) and other molecular tests can rapidly detect M. tuberculosis DNA.
Treatment
1. *Multidrug therapy*: A combination of antibiotics, typically isoniazid, rifampicin, pyrazinamide, and ethambutol, is used to treat TB.
2. *Long treatment duration*: Treatment typically lasts for 6 months or longer, depending on the case.
Challenges
1. *Drug resistance*: The emergence of multidrug-resistant TB (MDR-TB) and extensively drug-resistant TB (XDR-TB) poses significant challenges.
2. *Global burden*: TB remains a major public health problem worldwide, particularly in low- and middle-income countries.
Prevention
1. *BCG vaccine*: The Bacillus Calmette-Guérin (BCG) vaccine provides some protection against severe forms of TB, particularly in children.
2. *Infection control*: Measures such as ventilation, masks, and isolation can help prevent transmission.
Public Health Measures
1. *Surveillance*: Monitoring and tracking TB cases.
2. *Contact tracing*: Identifying and screening individuals who have been in contact with someone with TB.
3. *Education*: Public awareness campaigns on TB prevention and treatment.
M. tuberculosis is a complex pathogen that requires a comprehensive approach to control and eliminate TB. Ongoing research and development of new diagnostics, treatments, and vaccines are crucial to combating this disease.